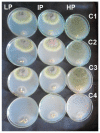
Figure 8

Copper-Chitosan Nanocomposite Hydrogels Against Aflatoxigenic Aspergillus flavus from Dairy Cattle Feed
- PMID: 32708303
- PMCID: PMC7559835
- DOI: 10.3390/jof6030112
Copper-Chitosan Nanocomposite Hydrogels Against Aflatoxigenic Aspergillus flavus from Dairy Cattle Feed
Abstract
The integration of copper nanoparticles as antifungal agents in polymeric matrices to produce copper polymer nanocomposites has shown excellent results in preventing the growth of a wide variety of toxigenic fungi. Copper-chitosan nanocomposite-based chitosan hydrogels (Cu-Chit/NCs hydrogel) were prepared using a metal vapor synthesis (MVS) and the resulting samples were described by transmission electron microscopy (TEM), X-ray fluorescence analysis (XRF), and small-angle X-ray scattering (SAXS). Aflatoxin-producing medium and VICAM aflatoxins tests were applied to evaluate their ability to produce aflatoxins through various strains of Aspergillus flavus associated with peanut meal and cotton seeds. Aflatoxin production capacity in four fungal media outlets revealed that 13 tested isolates were capable of producing both aflatoxin B1 and B2. Only 2 A. flavus isolates (Af11 and Af 20) fluoresced under UV light in the A. flavus and parasiticus Agar (AFPA) medium. PCR was completed using two specific primers targeting aflP and aflA genes involved in the synthetic track of aflatoxin. Nevertheless, the existence of aflP and aflA genes indicated some correlation with the development of aflatoxin. A unique DNA fragment of the expected 236 bp and 412 bp bands for aflP and aflA genes in A. flavus isolates, although non-PCR fragments have been observed in many other Aspergillus species. This study shows the antifungal activity of Cu-Chit/NCs hydrogels against aflatoxigenic strains of A. flavus. Our results reveal that the antifungal activity of nanocomposites in vitro can be effective depending on the type of fungal strain and nanocomposite concentration. SDS-PAGE and native proteins explain the apparent response of cellular proteins in the presence of Cu-Chit/NCs hydrogels. A. flavus treated with a high concentration of Cu-Chit/NCs hydrogels that can decrease or produce certain types of proteins. Cu-Chit/NCs hydrogel decreases the effect of G6DP isozyme while not affecting the activity of peroxidase isozymes in tested isolates. Additionally, microscopic measurements of scanning electron microscopy (SEM) showed damage to the fungal cell membranes. Cu-Chit/NCS hydrogel is an innovative nano-biopesticide produced by MVS is employed in food and feed to induce plant defense against toxigenic fungi.
Keywords: Aspergillus section Flavi; aflatoxins; chitosan; feeds; nanocomposites.
Conflict of interest statement
The authors declare no conflict of interest. The funders had a main role in the design of the study; in the collection, analyses, or interpretation of data; in the writing of the manuscript, or in the decision to publish the results.
Figures

References
-
- Almoammar H., Bahkali A.H., Abd-Elsalam K.A. A Polyphasic method for the identification of aflatoxigenic’aspergillus’ species isolated from camel feeds. Aust. J. Crop. Sci. 2013;7:1707.
-
- Omeiza G.K., Kabir J., Kwaga J.K.P., Kwanashie C.N., Mwanza M., Ngoma L. A Risk assessment study of the occurrence and distribution of aflatoxigenic Aspergillus flavus and Aflatoxin B1 in dairy cattle feeds in a Central Northern State, Nigeria. Toxicol. Rep. 2018;5:846–856. doi: 10.1016/j.toxrep.2018.08.011. - DOI - PMC - PubMed
-
- Mateo E.M., Gómez J.V., Domínguez I., Gimeno-Adelantado J.V., Mateo-Castro R., Gavara R., Jiménez M. Impact of bioactive packaging systems based on EVOH films and essential oils in the control of aflatoxigenic fungi and aflatoxin production In Maize. Int. J. Food Microbiol. 2017;254:36–46. doi: 10.1016/j.ijfoodmicro.2017.05.007. - DOI - PubMed
Grants and funding
LinkOut - more resources
Full Text Sources
Other Literature Sources

